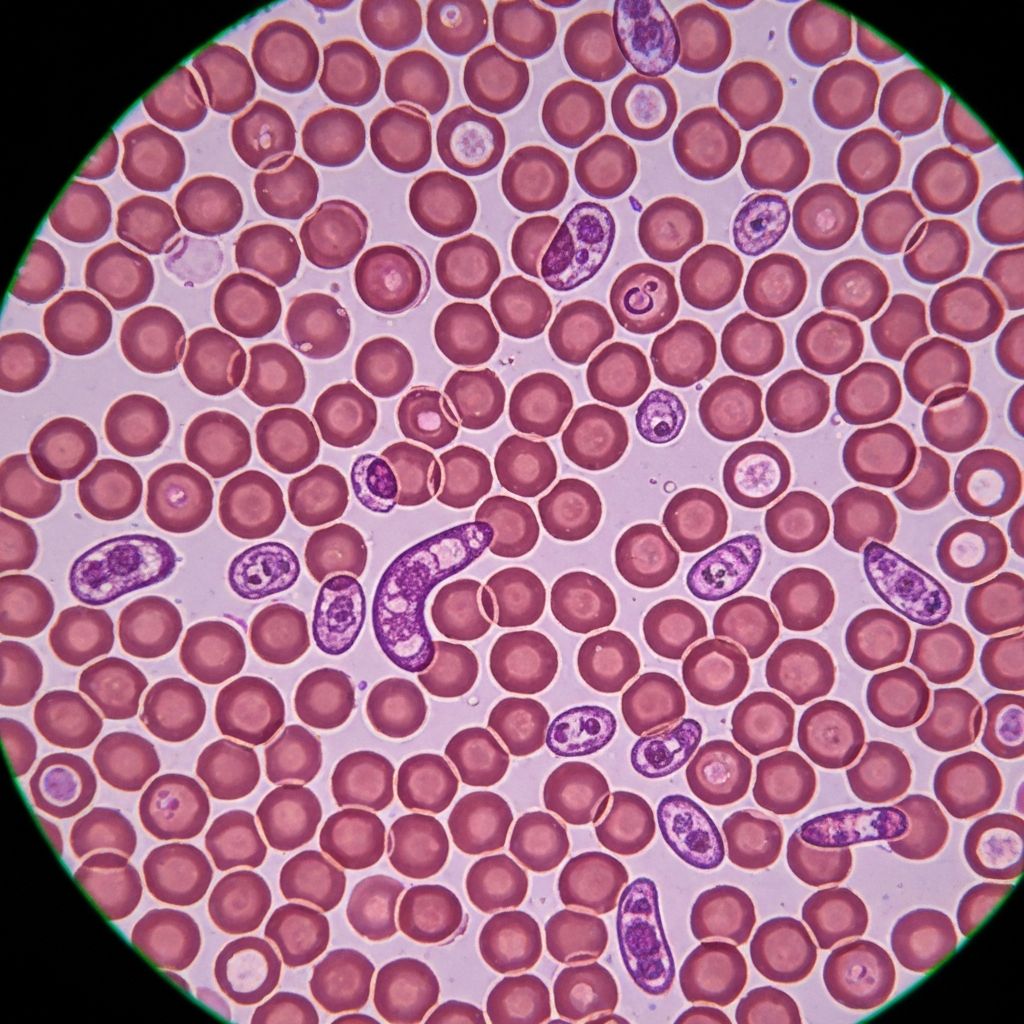
Parasitology

Comprehensive Diagnostic Services
From routine check-ups to specialized tests, we offer a complete range of diagnostic services with state-of-the-art equipment and expert professionals.

Clinical Chemistry
Analysis of blood and body fluids to evaluate organ function, metabolic status, and biochemical balance.
+12 more tests

Hematology
Detailed analysis of blood cells and clotting factors for diagnosis of blood disorders.
+9 more tests

Microbiology
Bacterial and fungal infection identification with culture sensitivity testing.
+8 more tests
Parasitology
Detection of parasitic infections affecting blood, urine, and stool.
+5 more tests

Serology & Immunology
Antibody detection for infections, autoimmune conditions, and immune responses.
+10 more tests

Hormonal & Endocrine
Comprehensive hormone level evaluation and endocrine gland function testing.
+13 more tests

Urinalysis & Stool
Routine urine and stool examinations for infections and metabolic conditions.
+8 more tests
Quick Results
Most routine test results within 24 hours
Tests Available
Comprehensive coverage for all diagnostic needs
Departments
Specialized units for accurate diagnostics


Ready to Take Control of Your Health?
Book your diagnostic test today and experience the Star Modern difference.